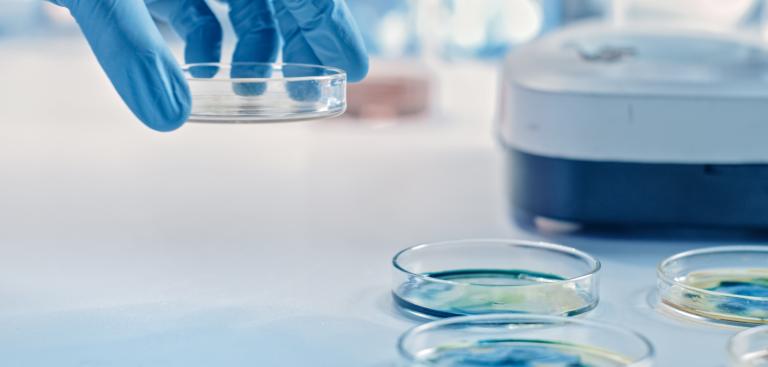
NAM Header

Applications
New Approach Methodologies: Bridging In Vitro and In Vivo Research
Advance your research with alternative research methods that connect cell-based and organoid testing to whole-animal validation.
Why New Approach Methodologies Matter in Modern Research
New Approach Methodologies (NAMs) are gaining momentum because they help researchers better capture human biology, improve predictive accuracy, and reduce reliance on less efficient legacy approaches. By combining technologies like organoid models, in vitro assays, and computational toxicology, NAMs offer more relevant and often faster insights into safety and efficacy.
Recognizing this potential, the U.S. Food and Drug Administration (FDA) actively supports the development and adoption of NAMs in drug discovery and safety assessment. The agency highlights that NAMs can improve translational relevance, reduce uncertainty in early-stage studies, and complement traditional approaches by refining the use of animal methods where needed.
Funding agencies are prioritizing New Approach Methodologies (NAMs) – including non-animal testing methods, organoid-based models, and predictive toxicology approaches – for their ethical advantages and translational relevance. But proposals that stop at in vitro models often fall short. The strongest grant applications connect NAMs to in vivo validation, increasing physiological impact. Pairing NAMs with targeted animal studies strengthens rigor, reproducibility, and translational power.

- Higher translatability: Link cell-based mechanisms to whole-animal outcomes.
- Rigor & reproducibility: Converging evidence across models reduces false positives.
- Smarter study design: Use alternative testing methods for early screening; confirm with in vivo validation.
- Efficient budgets & 3Rs: Align studies with the 3Rs (replacement, reduction, refinement) while maximizing funding impact.
Our Solutions for Alternative Testing Methods
We provide end-to-end workflows that connect in vitro discovery to in vivo validation, helping researchers design funding-ready, ethical, and translational studies.
Deliverables with NAMs and Predictive Toxicology Models
- A clear mechanism-to-outcome narrative
- Multiparametric readouts across cell-based and organoid testing platforms
- Ethical designs aligned to animal-free testing methods and modern grant criteria
Cell-Based and Organoid-Based Models for Early Discovery
- Multi Channel Systems: MEA platforms for electrophysiology in cellular and organoid-based models
- Biochrom: Spectrophotometers & amino acid analyzers for sample QC and metabolic profiling
- BTX: Gentle, reproducible gene and molecule delivery across multiple cell types
Ex Vivo Organ and Tissue Models for Translational Research
- Hugo Sachs Elektronik: Isolated organ & tissue systems for ex vivo function characterization
- CMA: Continuous in vivo sampling of neurotransmitters, hormones, and metabolites for mechanistic research
In Vivo Validation for Translational and Ethical Testing
- Data Sciences International (DSI): Implantable & external telemetry for real-time vital sign tracking
- Buxco Respiratory Products: Targeted assessment of lung function and compound delivery using invasive and non-invasive methods
- Panlab: Flexible behavioral testing and video tracking systems
Partner with Harvard Bioscience for NAMs and Animal-free Testing
With decades of expertise in electrophysiology, behavior, cardiovascular, respiratory, and fluidics, plus global technical support, we help you integrate New Approach Methodologies, organoid-based research, and predictive toxicology methods with in vivo validation.
We’re here to help. Contact us for questions or quoting information.